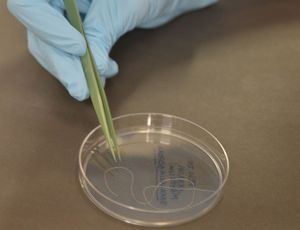

Previsão completa
Previsão completa

Tecnologia vai melhorar a responsividade do usuário

O software foi o segundo aplicativo nativo Xamarin mais baixado do Brasil, ficando atrás somente do aplicativo da Coca-Cola
Candidatos apontam caminhos diferentes para o setor

Número de domicílio com esse tipo de serviço mais que dobrou entre 2015 e 2018. Segundo André Borges, banda Ka trouxe um perfil residencial e é uma revolução em andamento

Para especialistas, nessa rede social predominam os conteúdos originais, que têm mais credibilidade

Nem só de futebol se faz o maior evento da atualidade... Pelo menos não para quem acompanha pela internet

Jogo virtual auxilia nos debates sobre combate ao bullying, indisciplina, saúde e trânsito
Erechim tem um veículo para cada 1,2 habitante
José e Jesus (2)
Calça jeans com bota cano curto
É difícil acreditar!
Sagrada Família de Nazaré: “Peregrinos de Esperança”
Nós e os índios
Eu sou o meu próprio obstáculo
Saudade ou saudosismo?